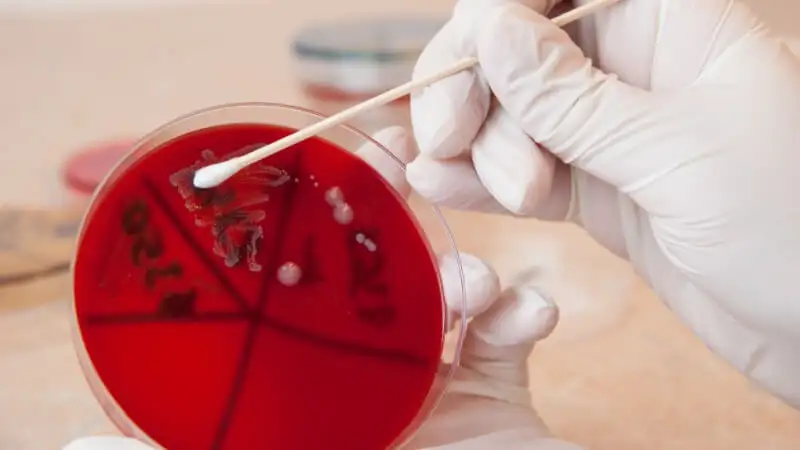

Enterococcus - groźne bakterie, które żyją w jelitach
1/9/2020
Gdzie można znaleźć bakterie Enterococcus?
Bakterie z rodzaju Enterococcus (tzw. enterokoki) wykrywa się we florze jelit oraz rzadziej w pochwie czy jamie ustnej. Najczęściej u ludzi występuje Enterococcus faecalis czy E. faecium.
Ich obecność w niektórych produktach uznawana jest za pożądaną - w śródziemnomorskich serach i wędlinach takich jak mozarella, feta, cheddar, machego, provolone, roquefort, pategros. Natomiast ze względu na oporność w trakcie obróbki termicznej (gotowanie, pasteryzację czy fermentację), wykorzystywane są jako wskaźnik higieny produkcji żywności.
Czy bakterie Enterococcus są we mnie?
Jako że Enterococcus są mieszkańcami naszych jelit, ich obecność w niewielkich ilościach nie jest jeszcze problemem. Dopiero pojawienie się dodatkowych czynników (szczególnie obniżenie odporności) stanowi zagrożenie, że zaczną się nadmiernie rozmnażać i prowadzić do kolonizacji innych układów i narządów.
Ilość enterokoków w jelitach można ocenić w badaniach mikroflory jelitowej:
Badania te polegają na laboratoryjnej ocenie próbki kału pod kątem:
- “dobrych” bakterii - Bifidobacterium, Lactobacillus,
- mikroorganizmów powodujących choroby - Proteus, Klebsiella, Candida, gronkowiec, E. coli, Pseudomonas, Clostridium,
- wskaźników stanów chorobowych - zonulina, kalprotektyna, obecność krwi utajonej w kale.
Z czego wynikają zakażenia enterokokami?
Bakterie Enterococcus powodują głównie zakażenia szpitalne, najczęściej u osób ze znacznie obniżoną odpornością. Szczególnie zagrożone mogą być również niemowlęta oraz osoby z cukrzycą. W szpitalach bakterie najczęściej przenoszone są pomiędzy pacjentami poprzez pracowników szpitala. Zakażenia te wiążą się z bardzo wysoką śmiertelnością.
Enterococcus są odporne na dużą liczbę antybiotyków. Oporność na antybiotyki może wynikać z nadmiernego podawania ich zwierzętom. Mają również zdolność do powodowania chorób dzięki pewnym właściwościom takim jak zdolność tworzenia biofilmu, wytwarzanie substancji o działaniu destrukcyjnym dla tkanek (kolagenaza, hemolizyna itp.).
Jak przebiega zakażenie Enterococcus?
Enterokoki po przedostaniu się do krwi nie tylko mogą spowodować zatrucie krwi i posocznicę, ale również prowadzą do zakażenia licznych układów i narządów:
- infekcje w obrębie jamy brzusznej i miednicy
- zakażenie dróg moczowych
- zapalenie wsierdzia i infekcja wyściółki serca,
- zapalenie płuc,
- enterokokowe zapalenie opon mózgowych
- zakażenia ran, szczególnie chirurgicznych i po oparzeniach,
- zapalenie kości, stawów i szpiku,
- zakażenia układu oddechowego,
- zakażenia miazgi zębowej i przyzębia.
Objawy będą ściśle uzależnione od lokalizacji, w której doszło do zakażenia. Mogą obejmować między innymi zmęczenie, skurcze żołądka, wymioty, bolesne oddawanie moczu.
Jak zapobiegać infekcji enterokokami?
- Osoby o obniżonej odporności powinny unikać spożywania fermentowanych wędlin i dojrzewających serów.
- Dokładna higiena rąk i stosowanie barier przy kontakcie z chorymi (np. maseczka, rękawiczki).
- Separowanie zakażonych pacjentów i pracowników opieki zdrowotnej.
- Badania pracowników szpitali w celu wykrycia ewentualnych zakażeń.
- Unikanie nadmiernego stosowania antybiotyków.
- Dokładne dbanie o czystość na terenie szpitali.
BIbliografia:
- Różańska H., Lewtak-Piłat A., Osek J.: Enterokoki – bakterie o wielu obliczach. Życie weterynaryjne 2013; 88 (7): 562-564.
- Pallares R., Grau I.: Gram positive bacteria – Enterococcus. Decision Support in Medicine, LLC 2017.
Autor merytoryczny: Mgr Katarzyna Startek, Dietetyk


